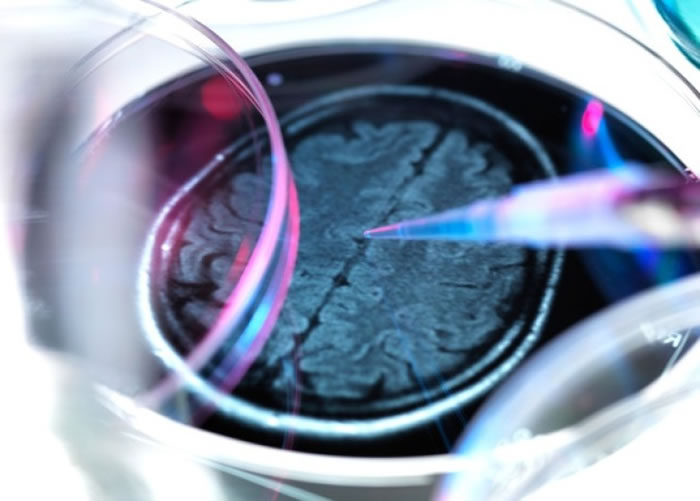
��Ч����²����� ����֪�ϰ�֢��ҩ��Aducanumab��������

有效清除致病蛋白 治认知障碍症新药“Aducanumab”将面世
有效清除致病蛋白 治认知障碍症新药“Aducanumab”将面世
(神秘的地球uux.cn报道)认知障碍症(又名脑退化症)困扰了不少年长人士,令他们的记忆及认知逐渐丧失。医学界一直努力找出清除致病的问题蛋白,美国生物科技公司Biogen及瑞士公司Neurimmune成功研发出一种清除问题蛋白的药物,若其功效最终获得确认,新药有望数年内面世,令医学界雀跃不已,形容是25年以来的最大喜讯,研究刊登于前天的英国《自然》期刊。
认知障碍症中最常见的是早老性痴呆症(Alzheimer's Disease),故研究邀请了165名患有轻度早老性痴呆症的患者参加。早老性痴呆症的致病原因,相信与淀粉状蛋白斑(Amyloid Plaque)在脑内形成,并阻碍脑细胞沟通有关,患者会丧失记忆及认知力。
在研究中,患者每月注射一次抗体药物“Aducanumab”,并按用药剂量多少分组,另有接受安慰治疗的患者作为对照。接受“Aducanumab”注射的患者,淀粉状蛋白斑会明显减少,而注射剂量越多,淀粉状蛋白斑消散越明显。其中注射剂量最多的一组,半年后病情已再无恶化,但不代表患者能恢复所失去的记忆。
另外,有40名患者要中途退出,当中一半是难忍头痛等副作用。医学界也对研究有保留,始终165名研究对象规模太少,而且尚未进入大型研究阶段。研究团体表示,研究即将进入第三阶段,并在全球招募2,700名研究对象。
即使充满变数,英国阿兹海默症协会首席研究员皮克特仍对研究乐观,他表示,如果Aducanumab能消除淀粉状蛋白斑,并阻慢病情恶化,确实是大跃进。英国兰开斯特大学神经科学教授阿尔索普亦相信,副作用终会解决。